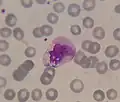
Imagen tomada con un microscopio óptico en la que se observa un monocito típico, su núcleo irregular y lobulado, con cromatina reticulada y citoplasma vacuolado. Tinción de May Grünwald-Giemsa.

Monocito
| Monocitos | ||
|---|---|---|
.jpg) Imagen tomada con un microscopio óptico en la que se observan 2 monocitos rodeados de glóbulos rojos y alguna plaqueta en un frotis sanguíneo. Tinción de Giemsa. | ||
 Representación 3D de un monocito. | ||
| Nombre y clasificación | ||
| Latín | Monocytus | |
| TH | H2.00.04.1.02010 | |
| TH | H2.00.04.1.02010 | |
| Información anatómica | ||
| Sistema | Fagocítico mononuclear | |
|
| ||
Los monocitos son un tipo de glóbulos blancos (leucocitos) agranulocitos. Es el leucocito de mayor tamaño, llegando a medir 18 μm, y representa del 2 al 8 % de los leucocitos en la sangre. El sistema fagocítico mononuclear (SFM) está constituido por los monocitos circulantes y los macrófagos tisulares. Los promonocitos de la médula ósea, al madurar salen de ella, diferenciándose en monocitos circulantes, que al cabo de unas 8 horas emigran a distintos tejidos, donde se convierten en macrófagos.
Características
Como características destacables, presenta un núcleo en general arriñonado, lobulado o cerebriforme, que se tiñe irregularmente en forma de "rejilla" o reticular de color violeta-azulado. Usualmente el núcleo guarda una proporción de 2:1 en área con respecto al citoplasma que lo rodea, y muy frecuentemente presenta una depresión profunda. El citoplasma es abundante y de color gris azulado pudiendo estar acompañado de vacuolas blanquecinas.
Origen
Los monocitos se generan en la médula ósea y después viajan por la sangre, para luego emigrar a diferentes tejidos como hígado, bazo, pulmones, ganglios linfáticos, huesos, cavidades serosas, etc. Después de alrededor de 24 horas de permanecer en el torrente sanguíneo, los monocitos lo abandonan y atraviesan el endotelio de los capilares o las vénulas poscapilares hacia el tejido conectivo, donde se diferencian rápidamente a macrófagos.
Funciones
Su principal función es la de fagocitar, es decir, comerse a diferentes microorganismos o restos celulares. Para fagocitar se tienen en cuenta diversos factores como la presencia de antígenos. No obstante, el procedimiento es sencillo, y consiste en rodear con los pseudópodos la molécula, acción que es inhibida en los casos en que el macrófago reconoce a la célula como integrante de un tejido propio del organismo, por medio de las proteínas del CMH (complejo mayor de histocompatibilidad) presentes sobre las membranas celulares.
Galería
-
Imagen tomada con un microscopio óptico en la que se observa un monocito típico, su núcleo irregular y lobulado, con cromatina reticulada y citoplasma vacuolado. Tinción de May Grünwald-Giemsa.
Imagen tomada con un microscopio óptico en la que se observa un monocito típico, su núcleo irregular y lobulado, con cromatina reticulada y citoplasma vacuolado. Tinción de May Grünwald-Giemsa. -
Imagen tomada con un microscopio óptico en la que se observa un monocito rodeado de glóbulos rojos y alguna plaqueta en un frotis sanguíneo. Tinción de Wright.
-
 Imagen de microscopía electrónica de barrido correspondiente a sangre circulante normal.
Imagen de microscopía electrónica de barrido correspondiente a sangre circulante normal.